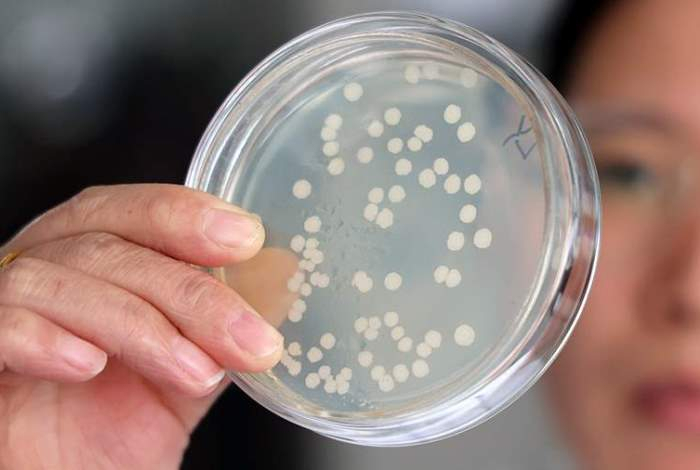

6 месяцев назад
Пробиотики — это полезные бактерии, которые естественным образом живут в кишечнике и помогают поддерживать его здоровье. Более подробно о том, какое влияние они оказывают на организм, «Известиям» 18 октября рассказала врач-гастроэнтеролог Валерия Антюфеева, передает Sports.kz.
Кол-во тэгов: 3
sports.kz 6 месяцев назад
Гастроэнтеролог сообщила о влиянии алкоголя на здоровье кишечника
 0
0 Кол-во тэгов: 3
sports.kz 4 месяца назад
«Эликсир жизни». Врач назвала напиток долголетия — подавляет гнилостные процессы в кишечнике
 0
0 Кол-во тэгов: 3
sports.kz 4 месяца назад
Добавьте этот продукт в йогурт и кишечник заработает как часы
 0
0